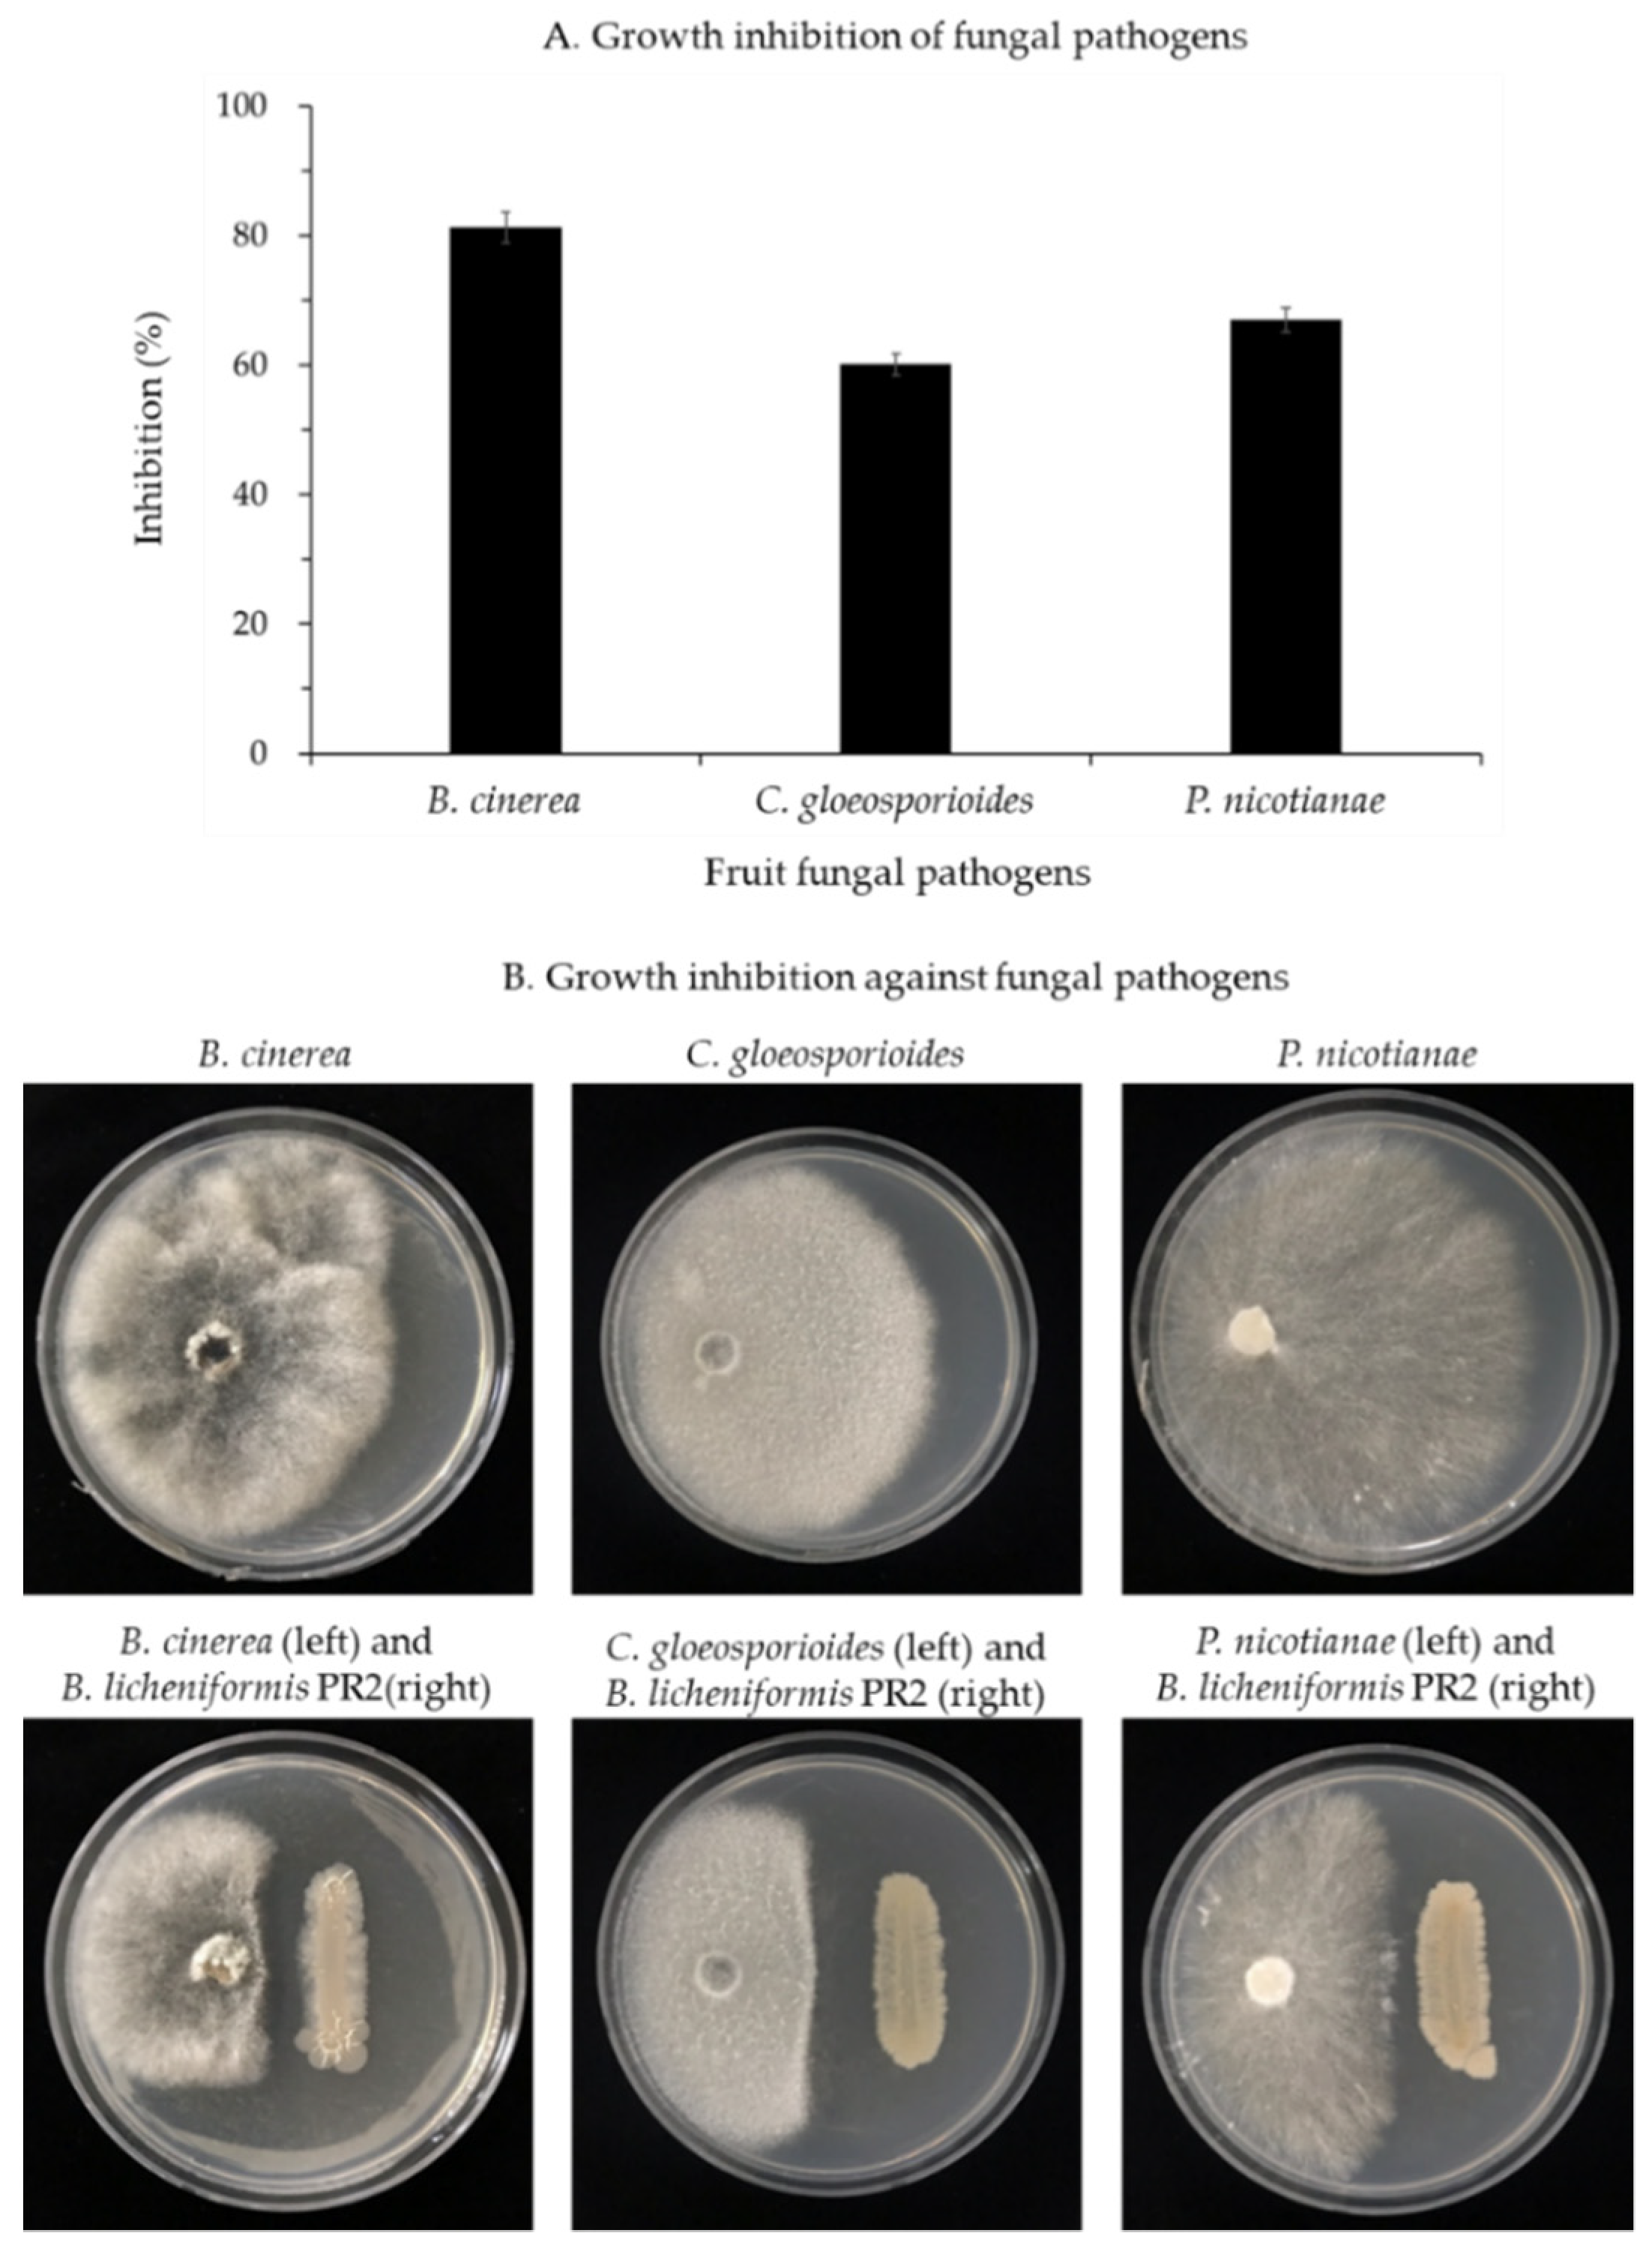
Horticulturae 07 00049 g003

Bacillus licheniformis PR2 Controls Fungal Diseases and Increases Production of Jujube Fruit under Field Conditions
Abstract
1. Introduction
2. Materials and Methods
2.1. Antagonistic Bacteria Growth
2.2. Production of Chitinase by B. licheniformis PR2
2.3. Inhibition of Fungal Pathogens by B. licheniformis PR2
2.4. Production of Indole-3-Acetic Acid (IAA) by B. licheniformis PR2
2.5. Descriptions of Study Area and Field Conditions
2.6. Chlorophyll Content Analysis and Jujube Fruit Production
2.7. Statistical Analysis
3. Results
3.1. Inhibition of Fungal Pathogens by B. licheniformis PR2
3.1.1. Changes in Chitinase Activity
3.1.2. Inhibition of Fungal Pathogen Growth by B. licheniformis PR2
3.2. Fruit Development by B. licheniformis PR2
3.2.1. Auxin Production
3.2.2. Chlorophyll Content
3.2.3. Fruit Rotting Rate, Characteristics, and Yields
4. Discussion
5. Conclusions
Author Contributions
Funding
Institutional Review Board Statement
Informed Consent Statement
Data Availability Statement
Conflicts of Interest
References
- Gao, Q.H.; Wu, C.S.; Wang, M. The jujube (Ziziphus jujuba Mill.) fruit: A review of current knowledge of fruit composition and health benefits. J. Agric. Food Chem. 2013, 61, 3351–3363. [Google Scholar] [CrossRef] [PubMed]
- Pareek, S. Nutritional composition of jujube fruit. Emir. J. Food Agric. 2013, 25, 463–470. [Google Scholar] [CrossRef]
- Wang, B.; Huang, Q.; Venkitasamy, C.; Chai, H.; Gao, H.; Cheng, N.; Cao, W.; Lv, X.; Pan, Z. Changes in phenolic compounds and their antioxidant capacities in jujube (Ziziphus jujuba Miller) during three edible maturity stages. LWT Food Sci. Technol. 2016, 66, 56–62. [Google Scholar] [CrossRef]
- Liu, M.J.; Zhao, Z.H. Germplasm resources and production of jujube in China. Acta Hortic. 2009, 840, 25–32. [Google Scholar] [CrossRef]
- Kwon, J.-H.; Won, S.-J.; Moon, J.-H.; Kim, C.-W.; Ahn, Y.-S. Control of fungal diseases and increase in yields of a cultivated jujube fruit (Zizyphus jujuba Miller var. inermis Rehder) orchard by employing Lysobacter antibioticus HS124. Forests 2019, 10, 1146. [Google Scholar] [CrossRef]
- Mirzaee, M.R. An overview of jujube (Zizyphus jujuba) diseases. Arch. Phytopathol. Plant Prot. 2014, 47, 82–89. [Google Scholar] [CrossRef]
- Yang, C.; Hamel, C.; Vujanovic, V.; Gan, Y. Fungicide: Modes of action and possible impact on nontarget microorganisms. ISRN Ecol. 2011, 2011, 130289. [Google Scholar] [CrossRef]
- Kookana, R.S.; Baskaran, S.; Naidu, R. Pesticide fate and behaviour in Australian soils in relation to contamination and management of soil and water: A review. Aust. J. Soil Res. 1998, 36, 715–764. [Google Scholar] [CrossRef]
- Wightwick, A.; Allinson, G. Pesticide residues in Victorian waterways: A review. Australas. J. Ecotox. 2007, 13, 91–112. [Google Scholar]
- Prusty, B.A.K. A book review on “Climate change and chemicals: Environmental and biological aspects”. Curr. Sci. India 2011, 100, 121–122. [Google Scholar]
- Komarek, M.; Cadkova, E.; Chrastny, V.; Bordas, F.; Bollinger, J.-C. Contamination of vineyard soils with fungicides: A review of environmental and toxicological aspects. Environ. Int. 2010, 36, 138–151. [Google Scholar] [CrossRef] [PubMed]
- Wightwick, A.M.; Mollah, M.R.; Partington, D.L.; Allinson, G. Copper fungicide residues in Australian vineyard soils. J. Agric. Food Chem. 2008, 56, 2457–2464. [Google Scholar] [CrossRef] [PubMed]
- Newman, P.; Jennings, I. Cities as Sustainable Ecosystems: Principles and Practices; Island Press: Washington, DC, USA, 2008; pp. 32–63. [Google Scholar]
- Rezai, G.; Teng, P.K.; Mohamed, Z.; Shamsudin, M.N. Consumers’ awareness and consumption intention towards green foods. Afr. J. Bus. Manag. 2012, 6, 4496–4503. [Google Scholar] [CrossRef]
- Esitken, A.; Karlidag, H.; Ercisli, S.; Sahin, F. Effects of foliar application of Bacillus subtilis Osu-142 on the yield, growth and control of shot-hole disease (Coryneum blight) of apricot. Gartenbauwissenschaft 2002, 67, 139–142. Available online: https://www.pubhort.org/ejhs/2002/file_3710.pdf (accessed on 21 December 2020).
- Glick, B.R. Plant growth-promoting bacteria: Mechanisms and applications. Scientifica 2012, 2012, 963401. [Google Scholar] [CrossRef] [PubMed]
- Glick, B.R. The enhancement of plant growth by free-living bacteria. Can. J. Microbiol. 1995, 41, 109–117. [Google Scholar] [CrossRef]
- Orhan, E.; Esitken, A.; Ercisli, S.; Turan, M.; Sahin, F. Effects of plant growth promoting rhizobacteria (PGPR) on yield, growth and nutrient contents in organically growing raspberry. Sci. Hortic. 2006, 111, 38–43. [Google Scholar] [CrossRef]
- Karlidag, H.; Esitken, A.; Turan, M.; Sahin, F. Effects of root inoculation of plant growth promoting rhizobacteria (PGPR) on yield, growth and nutrient element contents of leaves of apple. Sci. Hortic. 2007, 114, 16–20. [Google Scholar] [CrossRef]
- Ipek, M.; Pirlak, L.; Esitken, A.; Dönmez, M.F.; Turan, M.; Sahin, F. Plant growth-promoting rhizobacteria (PGPR) increase yield, growth and nutrition of strawberry under high-calcareous soil conditions. J. Plant Nutr. 2014, 37, 990–1001. [Google Scholar] [CrossRef]
- Park, H.-G.; Jeong, M.-H.; Ahn, Y.-S. Inoculation with Bacillus licheniformis MH48 to improve Camellia japonica seedling development in coastal lands. Turk. J. Agric. For. 2017, 41, 381–388. [Google Scholar] [CrossRef]
- Park, H.-G.; Lee, Y.-S.; Kim, K.-Y.; Park, Y.-S.; Park, K.-H.; Han, T.-H.; Park, C.-M.; Ahn, Y.S. Inoculation with Bacillus licheniformis MH48 promotes nutrient uptake in seedlings of the ornamental plant Camellia japonica grown in Korean reclaimed coastal land. Hortic. Sci. Technol. 2017, 35, 11–20. [Google Scholar] [CrossRef]
- Srivastava, A.; Handa, A.K. Hormonal regulation of tomato fruit development: A molecular perspective. J. Plant Growth Regul. 2005, 24, 67–82. [Google Scholar] [CrossRef]
- Gravel, V.; Antoun, H.; Tweddell, R.J. Growth stimulation and fruit yield improvement of greenhouse tomato plants by inoculation with Pseudomonas putida or Trichoderma atroviride: Possible role of indole acetic acid (IAA). Soil Biol. Biochem. 2007, 39, 1968–1977. [Google Scholar] [CrossRef]
- Hussain, A.; Hasnain, S. Interactions of bacterial cytokinins and IAA in the rhizosphere may alter phytostimulatory efficiency of rhizobacteria. World J. Microbiol. Biotechnol. 2011, 27, 2645–2654. [Google Scholar] [CrossRef]
- Liu, D.-J.; Chen, J.-Y.; Lu, W.-J. Expression and regulation of the early auxin-responsive Aux/IAA genes during strawberry fruit development. Mol. Biol. Rep. 2011, 38, 1187–1193. [Google Scholar] [CrossRef] [PubMed]
- Won, S.-J.; Choub, V.; Kwon, J.-H.; Kim, D.-H.; Ahn, Y.-S. The control of fusarium root rot and development of coastal pine (Pinus thunbergii Parl.) seedlings in a container nursery by use of Bacillus licheniformis MH48. Forests 2019, 10, 6. [Google Scholar] [CrossRef]
- Won, S.-J.; Kwon, J.-H.; Kim, D.-H.; Ahn, Y.-S. The effect of Bacillus licheniformis MH48 on control of foliar fungal diseases and growth promotion of Camellia oleifera seedlings in the coastal reclaimed land of Korea. Pathogens 2019, 8, 6. [Google Scholar] [CrossRef]
- Medrano, H.; Escalona, J.M.; Cifre, J.; Bota, J.; Flexas, J. A ten-year study on the physiology of two Spanish grapevine cultivars under field conditions: Effects of water availability from leaf photosynthesis to grape yield and quality. Funct. Plant Biol. 2003, 30, 607–619. [Google Scholar] [CrossRef] [PubMed]
- Baset Mia, M.A.; Shamsuddin, Z.H.; Wahab, Z.; Marziah, M. Effect of plant growth promoting rhizobacterial (PGPR) inoculation on growth and nitrogen incorporation of tissue-cultured Musa plantlets under nitrogen-free hydroponics condition. Aust. J. Crop Sci. 2010, 4, 85–90. [Google Scholar]
- Ramamoorthy, V.; Viswanathan, R.; Raguchander, T.; Prakasam, V.; Samiyappan, R. Induction of systemic resistance by plant growth promoting rhizobacteria in crop plants against pests and diseases. Crop Prot. 2001, 20, 1–11. [Google Scholar] [CrossRef]
- Vivekananthan, R.; Ravi, M.; Ramanathan, A.; Samiyappan, R. Lytic enzymes induced by Pseudomonas fluorescens and other biocontrol organisms mediate defence against the anthracnose pathogen in mango. World J. Microbiol. Biotechnol. 2004, 20, 235–244. [Google Scholar] [CrossRef]
- Arikan, S.; Pirlak, L. Effects of plant growth promoting rhizobacteria (PGPR) on growth, yield and fruit quality of sour cherry (Prunus cerasus L.). Erwerbs-Obstbau 2016, 58, 221–226. [Google Scholar] [CrossRef]
- Lingappa, Y.; Lockwood, J. Chitin media for selective isolation and culture of actinomycetes. Phytopathology 1962, 52, 317–323. [Google Scholar]
- Rahman, A.; Sitepu, I.R.; Tang, S.-Y.; Hashidoko, Y. Salkowski’s reagent test as a primary screening index for functionalities of rhizobacteria isolated from wild dipterocarp saplings growing naturally on medium-strongly acidic tropical peat soil. Biosci. Biotechnol. Biochem. 2010, 74, 2202–2208. [Google Scholar] [CrossRef]
- Gomaa, E.Z. Chitinase production by Bacillus thuringiensis and Bacillus licheniformis: Their potential in antifungal biocontrol. J. Microbiol. 2012, 50, 103–111. [Google Scholar] [CrossRef]

| Treatment | Fruit Rotting Rate (%) | Fruit Characteristics (mm) | Fruit Yield (kg/Tree) | |
|---|---|---|---|---|
| Length | Diameter | |||
| Control | 40.4 ± 7.9 * | 33.1 ± 3.9 * | 25.7 ± 2.8 * | 5.6 ± 2.9 * |
| Bacterial inoculation | 13.3 ± 4.8 * | 38.5 ± 2.5 * | 29.9 ± 2.4 * | 17.9 ± 8.2 * |
Publisher’s Note: MDPI stays neutral with regard to jurisdictional claims in published maps and institutional affiliations. |
© 2021 by the authors. Licensee MDPI, Basel, Switzerland. This article is an open access article distributed under the terms and conditions of the Creative Commons Attribution (CC BY) license (http://creativecommons.org/licenses/by/4.0/).
Share and Cite
Kwon, J.-H.; Won, S.-J.; Moon, J.-H.; Lee, U.; Park, Y.-S.; Maung, C.E.H.; Ajuna, H.B.; Ahn, Y.S. Bacillus licheniformis PR2 Controls Fungal Diseases and Increases Production of Jujube Fruit under Field Conditions. Horticulturae 2021, 7, 49. https://doi.org/10.3390/horticulturae7030049
Kwon J-H, Won S-J, Moon J-H, Lee U, Park Y-S, Maung CEH, Ajuna HB, Ahn YS. Bacillus licheniformis PR2 Controls Fungal Diseases and Increases Production of Jujube Fruit under Field Conditions. Horticulturae. 2021; 7(3):49. https://doi.org/10.3390/horticulturae7030049
Chicago/Turabian StyleKwon, Jun-Hyeok, Sang-Jae Won, Jae-Hyun Moon, Uk Lee, Yun-Serk Park, Chaw Ei Htwe Maung, Henry B. Ajuna, and Young Sang Ahn. 2021. "Bacillus licheniformis PR2 Controls Fungal Diseases and Increases Production of Jujube Fruit under Field Conditions" Horticulturae 7, no. 3: 49. https://doi.org/10.3390/horticulturae7030049
APA StyleKwon, J.-H., Won, S.-J., Moon, J.-H., Lee, U., Park, Y.-S., Maung, C. E. H., Ajuna, H. B., & Ahn, Y. S. (2021). Bacillus licheniformis PR2 Controls Fungal Diseases and Increases Production of Jujube Fruit under Field Conditions. Horticulturae, 7(3), 49. https://doi.org/10.3390/horticulturae7030049

